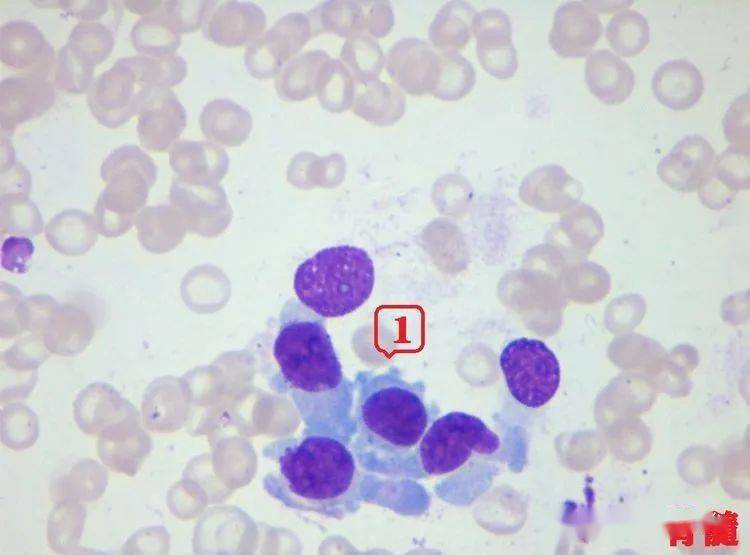
看图识细胞第90期

球旁细胞图片

尿极 血管球 远曲小管 球旁细胞 近曲小管 血管极 第14页 (共21页
图片尺寸1080x810
肾小球旁细胞
图片尺寸268x268
肾素(renin)是球旁细胞释放的一种蛋白水解酶.
图片尺寸750x766
一例"球形红细胞增多"的思考
图片尺寸650x612
细胞质 叶 绿 体 细胞核
图片尺寸1080x810
管-球反馈 | sglt2 抑制剂护肾的主要机制_细胞
图片尺寸1080x1015
每日一拍
图片尺寸720x960
细胞水平检测
图片尺寸400x260
但未做鉴定,然互6天后传代,第一天正常,第三天发现细胞贴壁了,球状的
图片尺寸4032x3024
球旁细胞 它是入球微动脉接近血管球处,由入球微动脉管壁的平滑肌变形
图片尺寸958x991
16翻译一下图片中的英文,把汉语意义写出来,注意是
图片尺寸717x539
肾脏球旁细胞瘤临床病理学特征
图片尺寸807x393
2018细胞形态学培训考试答案版
图片尺寸698x518
肺泡隔内没有腺垂体分为根据白细胞胞质有无颗粒,可将其分为有粒白
图片尺寸1920x1080
【泌尿生理】球旁器_致密斑,颗粒细胞,球外系膜细胞_哔哩哔哩_bili
图片尺寸1890x1181
看图识细胞第90期
图片尺寸750x555
成人肾球旁细胞瘤病理图谱
图片尺寸661x493
成人肾球旁细胞瘤病理图谱
图片尺寸661x493
图,室内,特写,白天,正面,微生物,阴影,反射,科学,医学,纹路,纹理,细胞
图片尺寸819x539
绿色似刺球细胞 - 素材公社 tooopen.com
图片尺寸1024x768